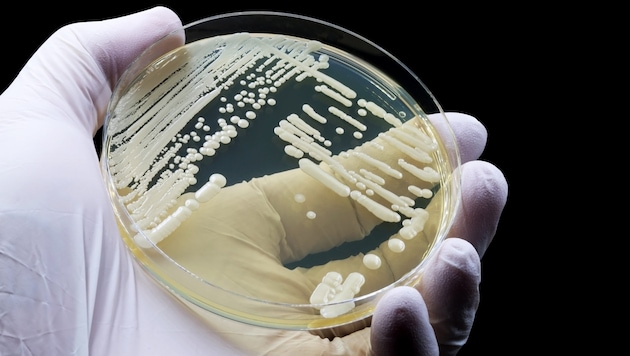
Den Pilz kann man jahrelang mit sich herumtragen, ohne es zu merken, warnen Forscher.

Blutvergiftung droht
Tödlicher Pilz sucht Europas Spitäler heim
Candidozyma auris gilt als extrem ansteckend und resistent. Mittlerweile hat sich der Erreger auch in Europa und sogar Österreich verbreitet. Das Problem: Viele Anti-Pilz-Mittel wirken bei ihm nicht.
Im Grunde genommen sind Pilze nichts Ungewöhnliches – sie sind überall an und in unserem Körper zu finden. Problematisch wird der Befall lediglich bei wenigen Arten, wie beispielsweise Hautpilzen, Hefen und einigen Schimmelpilzen. Candidozyma auris, 2019 in Japan entdeckt, verbreitet sich rasch und kann lebensgefährlich werden. Laut dem Europäischen Zentrum für die Prävention und die Kontrolle von Krankheiten (ECDC) wurde die Infektion auf unserem Kontinent in Spanien, Griechenland, Italien und Rumänien am häufigsten nachgewiesen.
Candidozyma auris kann von Mensch zu Mensch per Schmierinfektion weitergegeben werden, hält sich hartnäckig auf Oberflächen und ist nur schwer zu entfernen, heißt es. „Der wichtigste Übertragungsweg sind Geräte, die schlecht desinfizierbar sind und die an mehreren Patienten eingesetzt werden“, erklärt Oliver Kurzai, Leiter des Instituts für Hygiene und Mikrobiologie an der Julius-Maximilians-Universität Würzburg, in einem Presse-Briefing.
Immunschwache, aufgepasst!
Ansiedeln könne sich der Hefepilz auf der Haut. Brenzlig wird der Befall demnach bei einem geschwächten Immunsystem – dann könne er sich im Körper ausbreiten, in die Blutbahn gelangen und dort eine Blutvergiftung auslösen. Fast jeder zweite Patient überlebe einen solchen Verlauf nicht.
Als gefährdet gelten frisch Operierte, Ältere, Frühgeborene und kranke Menschen. „Das sind immungeschwächte Patienten, die eine Krebserkrankung haben, die frisch operiert sind, die chronisch krank sind, zum Beispiel eine Nierendialyse benötigen“, führte Georg-Christian Zinn, Direktor des Hygienezentrums Bioscientia, bei RTL aus.
Zur Vorbeugung gilt die richtige Handhygiene als das A und O. Bedacht werden muss demzufolge, dass nicht alle Desinfektionsmittel dem Pilz Einhalt gebieten können. Effizient seien insbesondere alkoholische.

Kronen Zeitung als bevorzugte Google-Quelle hinzufügen
Kronen Zeitung als bevorzugte Google-Quelle hinzufügen 



















Willkommen in unserer Community! Eingehende Beiträge werden geprüft und anschließend veröffentlicht. Bitte achten Sie auf Einhaltung unserer Netiquette und AGB. Für ausführliche Diskussionen steht Ihnen ebenso das krone.at-Forum zur Verfügung. Hier können Sie das Community-Team via unserer Melde- und Abhilfestelle kontaktieren.
User-Beiträge geben nicht notwendigerweise die Meinung des Betreibers/der Redaktion bzw. von Krone Multimedia (KMM) wieder. In diesem Sinne distanziert sich die Redaktion/der Betreiber von den Inhalten in diesem Diskussionsforum. KMM behält sich insbesondere vor, gegen geltendes Recht verstoßende, den guten Sitten oder der Netiquette widersprechende bzw. dem Ansehen von KMM zuwiderlaufende Beiträge zu löschen, diesbezüglichen Schadenersatz gegenüber dem betreffenden User geltend zu machen, die Nutzer-Daten zu Zwecken der Rechtsverfolgung zu verwenden und strafrechtlich relevante Beiträge zur Anzeige zu bringen (siehe auch AGB). Hier können Sie das Community-Team via unserer Melde- und Abhilfestelle kontaktieren.